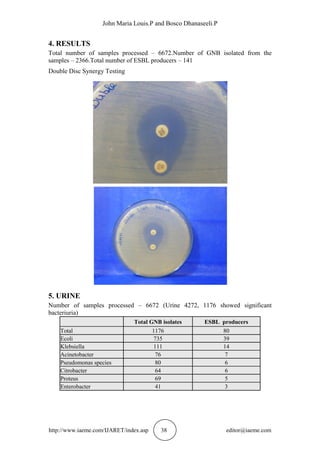
John Maria Louis.P and Bosco Dhanaseeli.P
http://www.iaeme.com/IJARET/index.asp 38 editor@iaeme.com
4. RESULTS
Total number of samples processed – 6672.Number of GNB isolated from the
samples – 2366.Total number of ESBL producers – 141
Double Disc Synergy Testing
5. URINE
Number of samples processed – 6672 (Urine 4272, 1176 showed significant
bacteriuria)
Total GNB isolates ESBL producers
Total 1176 80
Ecoli 735 39
Klebsiella 111 14
Acinetobacter 76 7
Pseudomonas species 80 6
Citrobacter 64 6
Proteus 69 5
Enterobacter 41 3

This study investigated the prevalence of extended-spectrum beta-lactamase (ESBL)-producing gram-negative bacilli at a tertiary care hospital over one year. A total of 6,672 clinical samples were tested, yielding 2,366 gram-negative bacteria isolates. Phenotypic confirmation testing found 141 isolates (5.95%) to be ESBL producers. The most common ESBL-producing organisms were Escherichia coli (6.43% of E. coli isolates) and Klebsiella pneumoniae (10.97% of K. pneumoniae isolates). The results suggest a high prevalence of ESBL producers in this hospital setting. Improved antibiotic stewardship and infection control practices are needed to
![http://www.iaeme.com/IJARET/index.asp 36 editor@iaeme.com
International Journal of Advanced Research in Engineering and Technology
(IJARET)
Volume 6, Issue 10, Oct 2015, pp. 36-41, Article ID: IJARET_06_10_008
Available online at
http://www.iaeme.com/IJARET/issues.asp?JType=IJARET&VType=6&IType=10
ISSN Print: 0976-6480 and ISSN Online: 0976-6499
© IAEME Publication
___________________________________________________________________________
A STUDY ON THE PREVALENCE OF ESBL
PRODUCING GRAM NEGATIVE BACILLI
IN A TERTIARY CARE HOSPITAL
John Maria Louis. P and Bosco Dhanaseeli. P
Department of microbiology, Chettinadu Academy of Research and Education
Department of chemistry, AMET University, Chennai
ABSTRACT
The resistance to broad spectrum β-lactams which is mediated by the
extended spectrum beta lactamase (ESBL) enzyme is an increasing problem
now-a-days. This resistance mechanism has been responsible for nosocomial
outbreaks, serious therapeutic failure if it is not detected on time and the
outbreak of multidrug resistant, gram negative pathogens that need expensive
control measures. As no data was available on the prevalence of ESBL in this
region, the current study was undertaken to determine the prevalence of the
ESBL producing strains in our hospital
Key words: Extended Spectrum Beta Lactamase, Prevalence, ABST, GNB,
Phenotypic Confirmation Test.
Cite this Article: John Maria Louis.P and Bosco Dhanaseeli.P. A Study on
the Prevalence of ESBL Producing Gram Negative Bacilli in a Tertiary Care
Hospital. International Journal of Advanced Research in Engineering and
Technology, 6(10), 2015, pp. 36-41.
http://www.iaeme.com/IJARET/issues.asp?JType=IJARET&VType=6&IType=10
1. INTRODUCTION
The ever-increasing bacterial resistance to antibiotics is one of the most challenging
tasks of all the medical issues which are being faced by us today. A single mutation in
bacteria which leads to a new resistance mechanism against various drugs is like
undoing within moments, the great efforts in developing these drugs; of a great mind.
Infection with Drug resistant organisms is a major public health issue. Evolution of
resistance to beta lactam antibiotics in Gram negative pathogens results from the
production of beta lactamases which can hydrolyse the beta lactam ring. Beta
lactamases are a group of enzymes produced by several Gram negative organisms that
inactivate the drugs that belongs to penicillin and cephalosporin group and render
them in effective[1-2]. ESBL – Extended Spectrum Beta Lactamases were first
described in Klebsiella species and then in Ecoli and other genera. ESBL are a group](https://image.slidesharecdn.com/ijaret0610008-151107080914-lva1-app6891/85/Ijaret-06-10_008-1-320.jpg)
![A Study on The Prevalence of ESBL Producing Gram Negative Bacilli In A Tertiary Care
Hospital
http://www.iaeme.com/IJARET/index.asp 37 editor@iaeme.com
of enzymes that mediate resistance to extended spectrum (3rd generation)
cephalosporins and monobactams [3-4] .ESBLs are rapidly evolving, undergoing
continuous mutation.More than 300 different ESBL variants. TEM, SHV and CTX M
are the common types[5-6].Important cause of transferable multi drug resistance in
GNB.So it is important that ESBL should be detected in organisms in hospitals and
health care settings. ESBLs belong to Molecular class A, in the classification scheme
of Ambler. Functional group 2be in Bush Jacoby Medeiros classification [7-8].
The persistent exposure of the bacterial strains to a multitude of β-lactams has
induced a dynamic and continuous production and mutation of β-lactamases in the
bacteria, expanding their activity even against the third and fourth generation
cephalosporins such as ceftazidime, cefotaxime and cefepime and also against
aztreonam. These new β-lactamases are called extended spectrum β-lactamases
(ESBLs) [9-10].
ESBL enzymes are plasmid borne and they have evolved from point mutations
which altered the configuration of the active site of the original and long known β-
lactamases, which have been designated as TEM-1, TEM-2, and SHV-1 [11]. The
resistance to newer β-lactams which are a result of these ß-lactamases, has emerged
quickly.
2. AIM OF THIS STUDY
To determine the prevalence of ESBL producing strains of Gram Negative Bacilli
among GNB isolates from clinical samples. Detection of ESBL production by
phenotypic methods
3. MATERIALS AND METHODS
Study period – 1 year. Clinical samples included in this study - urine, blood, pus,
wound swab, sputum, and ET aspirate. Informed consent was obtained from the
patients prior to sample collection. GNB isolates from the samples mentioned above
were subjected to antibiotic sensitivity testing by Kirby Bauer disc diffusion method.
The initial screening test was performed along with the routine ABST by the routine
Kirby Bauer disc diffusion method. The screening test was positive when the
inhibition zone of < 27 mm for Cefotaxime was observed.
3.1. Antibiotic Panel Used For Routine Sensitivity Testing
The strains were tested for susceptibility against Ampicillin(10μg), Gentamicin
(10μg), Amikacin(10μg), Cefotaxime(30μg),Netilmicin(30μg),Cefazolin (30μg),
Cefuroxime(30μg) Cefepime(30μg), Ciprofloxacin(30μg), Norfloxacin(30μg),
Nitrofurantoin (30μg), Imipenem (10μg),Meropenem(10μg), Cotrimoxazole (30μg),
Piperacillin tazobactam (30μg)
Phenotypic confirmation test was performed by the Double Disc synergy testing
method as follows. A Mueller Hinton agar culture plate was inoculated with a lawn of
0.5 Mc Farland turbidity of the strain to be tested. Piperacillin tazobactam (100/10 µg)
disc was placed in the centre of a Mueller Hinton culture plate and a disc of
Cefotaxime was placed at a distance of 15mm apart from the Pip Taz disc. Any
distortion or increase in the zone towards the disc of Pip Tazo was considered as
positive for the ESBL production.](https://image.slidesharecdn.com/ijaret0610008-151107080914-lva1-app6891/85/Ijaret-06-10_008-2-320.jpg)

![John Maria Louis.P and Bosco Dhanaseeli.P
http://www.iaeme.com/IJARET/index.asp 40 editor@iaeme.com
8. DISCUSSION
In the recent years, the problem of increasing resistance to antibiotic has threatened
the entire world. The correct detection of ESBL producing microorganisms is a
challenge for the laboratories, as it requires not only phenotypic test also genotypic
test for all genes associate with β-lactamases production. A total of 6672 samples
were processed of which 2366 yielded Gram negative bacilli. In this study E coli
(933) and Klebsiella (319) were the most prevalent isolates among the Gram negative
bacilli. The prevalence of ESBL producing GNB was found to be 5.95%. In E coli the
ESBL prevalence was 6.43 % and in Klebsiella it was 10.97%.
9. CONCLUSION
There is a high prevalence of ESBL production in our hospital and so, it is essential to
report the ESBL production along with the routine sensitivity reports, which will help
the clinician in prescribing proper antibiotics. Also, control measures which include
the judicious use of antibiotics, antibiotic cycling, and the implementation of
appropriate infection control measures and the formulation of an antibiotic policy
must be done, to prevent the spread of these strains.
REFERENCES
[1] Medeiros AA. Evolution and dissemination of β-lactamases accelerateis by
generation of β-lactam antibiotics. Clin Infect Did 1997; 24 Suppl 1: S19-
S45.
[2] Bush K. New β-lactamases in gram-negative bacteria: diversit and impact on
the selection of antimicrobial therap. Clin Infect Dis 2001; 32: 1085-9.
[3] Wong- Beringer A. Therapeutic challenges associated with extended-
spectrum, β-lactamases-producing Escherichia coli and klebsiella pneumonia.
Pharmacotherapy 2001; 21: 583-92.
[4] Patterson DL. Extended- spectrum β-lactamases: the European experience.
Curr Opin Infect Dis 2001; 14: 69-01.
[5] Burgess DS. Comparison of in vitro activity of
piperacillin/tazobactam,cefepime, imipenem, and meropenem against
extended- spectrum β-lactamase (ESBL) and non-ESBL producing
K.pneumoniae by time- kill methodology[abstr]. Pharmacotherapy 2001;
21:1273.
[6] Rebuck JA, Keith M, Olsen KM, Fey PD, Bergmann KL, Rupp ME. In vitro
activities of parenteral β-lactam antimicrobial against TEM-10, TEM-26 and
SHV-5-derived extended- spectrum β-lactamases expressed in an isogenic
Escherichia coli host. J Antimicrob Chemother 2000; 46: 461-4.
[7] Coudron PE, Moland ES, Thomson KS. Occurrence and detection of AmpC
β-lactamases among Escherichia coli, Klebsiella pneumoniae, and Proteus
mirabilis isolates at a veterans medical center.J Clin Microbiol 2003;38:
1791-6.
[8] Queenan AM, Jenkins S, Bush K. Cloning and biochemical characterization
of FOX-5, an AmpC- type plasmid – encoded β-lactamases from a New York
City Klebsiella pneumoniae clinical isolate. Antimicrob Agents Chemother
2001; 45: 3189-94.
[9] National Committee for Clinical Laboratory Standards. Methods for dilution:
antimicrobial susceptibility test for bacteria that grow aerobically: approved](https://image.slidesharecdn.com/ijaret0610008-151107080914-lva1-app6891/85/Ijaret-06-10_008-5-320.jpg)
![A Study on The Prevalence of ESBL Producing Gram Negative Bacilli In A Tertiary Care
Hospital
http://www.iaeme.com/IJARET/index.asp 41 editor@iaeme.com
standard, 5th
ed. NCCLS document M7-A5. Wayne, PA: National Committee
for Clinical Laboratory Standards, 2000.
[10] Bali EB, Acik L, Sultan N. Phenotypic and molecular characterization of
SHV, TEM, CTX-M and extended spectrum β-lactamase produced by
Escherichia coli, Acinetobacter baumanii and Klebsiella isolates in a Turkish
hospital. Afr. J. Microbiol. Res. 2010; 4(8): 650-654
[11] Samaha-Kfoury J N, Araj G F. Recent developments in β-lactamases and
extended spectrum β-lactamases. BMJ 2003; 327:1209-13.
[12] Dr. Satpal Singh and Dr. Pankaj, Health Care Quality Assurance: Emergency
Department of A Tertiary Care Hospital, International Journal of Advanced
Research in Management 4(1), 2013, pp. 31 - 41.](https://image.slidesharecdn.com/ijaret0610008-151107080914-lva1-app6891/85/Ijaret-06-10_008-6-320.jpg)